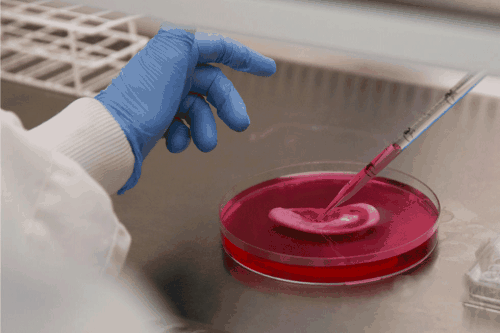

2016-2022 All Rights Reserved.平安財經網.復制必究 聯系QQ 備案號:
本站除標明“本站原創”外所有信息均轉載自互聯網 版權歸原作者所有。
郵箱:toplearningteam#gmail.com (請將#換成@)
科學家使用人體細胞3D在眼睛上方打印了薄薄的保護膜,稱為角膜 - 而且它是人造角膜的最先進版本。如果技術得到改善,它可以幫助數百萬人再次看到。
紐卡斯爾大學的組織工程師Che Connon說,找到適合墨水的配方非常難以噴出3D打印機的噴嘴,他是人工角膜的創造者之一。這種生物墨水不僅需要很薄 - 它還必須足夠堅硬才能保持其3D形狀的形狀。為了獲得正確的一致性,研究人員添加了一種類似果凍的粘液,稱為藻酸鹽和從供體角膜中提取的干細胞,以及一些稱為膠原蛋白的粘蛋白。
角膜是第一個透鏡光在最終撞擊眼睛后部的視網膜之前穿過的。角膜損傷 - 受傷或感染 - 可能會扭曲視力,甚至導致失明。目前,受損的角膜被來自已故捐獻者的健康角膜取代,但沒有足夠的捐贈角膜可供使用。世界衛生組織表示,全世界有近500萬人因為感染傷口角膜而失明。
今天在實驗眼科研究期刊中描述的新技術并沒有完全消除對角膜捐贈的需求 - 這些是制作干細胞配方的關鍵。但是,使用這種技術,捐贈進一步發展,Connon說。不是用一個健康的角膜替換一個受損的角膜,而是可以從一個捐贈的角膜中生長出足夠的細胞來印刷50個人造角膜。
為了弄清楚究竟要打印什么,團隊還必須弄清楚人類角膜的形狀。因此,研究人員使用特殊的相機對志愿者的眼球進行成像,并創建角膜的3D模型。然后,團隊將該模板送入3D打印機,該打印機將生物墨水噴射到Jello的支撐床上以形成角膜。結果看起來像粘性浴中的軟性隱形眼鏡。
但是,在這些人造角膜甚至接近人眼之前還有很長的路要走:康農希望首先對印刷過程進行微調,他說,人造角膜還需要經過動物安全研究。但是這項研究證明你可以 3D打印看起來像角膜的東西,并且含有大部分相同的成分。這也是研究人員第一次重建角膜獨特的彎曲形狀。康農說這是人造角膜工作的關鍵:“沒有形狀,你沒有角膜 - 你還有別的東西。”
2016-2022 All Rights Reserved.平安財經網.復制必究 聯系QQ 備案號:
本站除標明“本站原創”外所有信息均轉載自互聯網 版權歸原作者所有。
郵箱:toplearningteam#gmail.com (請將#換成@)